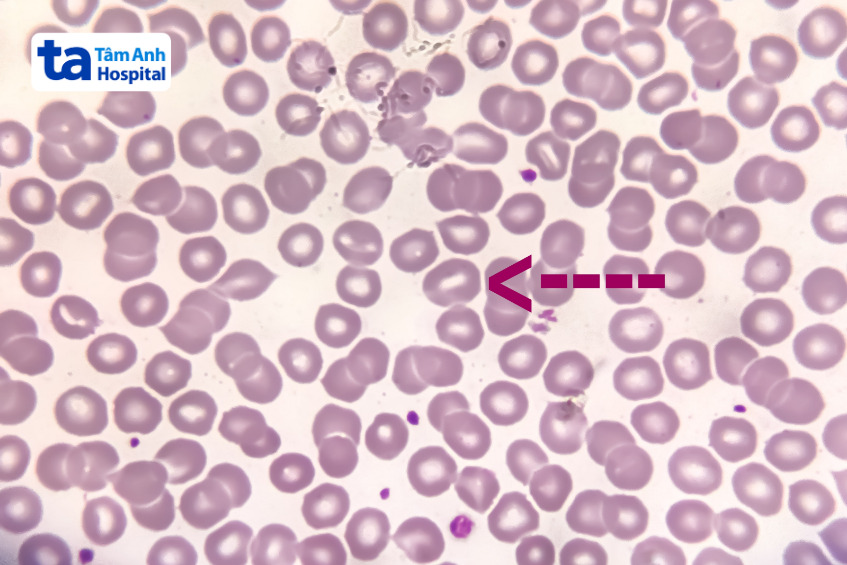
hình ảnh hồng cầu hình miệng (mũi tên trong hình)
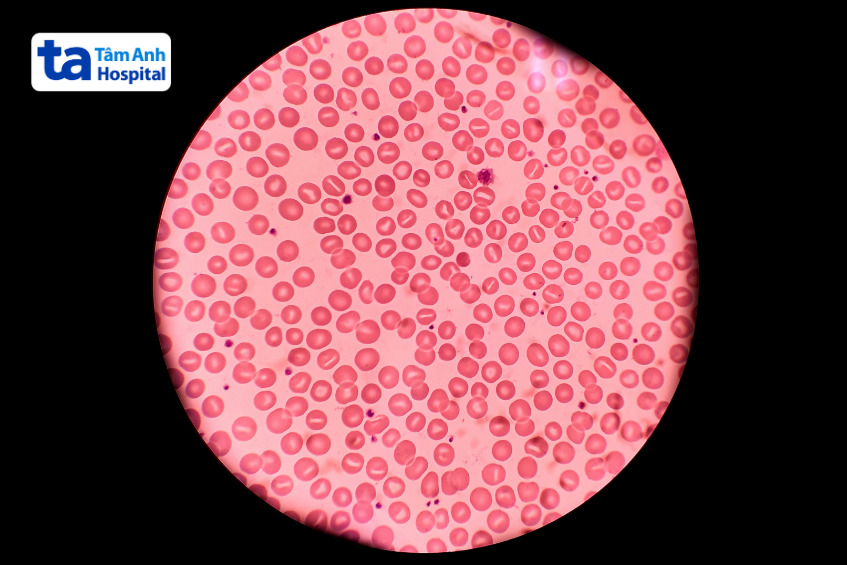
tỷ lệ tế bào hồng cầu stomatocyte trong xét nghiệm phết máu ngoại vi

Bệnh hồng cầu hình miệng di truyền ít gặp nhưng có thể ảnh hưởng đến sức khỏe, dẫn đến triệu chứng bất lợi. Vậy, nguyên nhân gây bệnh hồng cầu hình miệng là gì? Làm sao để nhận biết dấu hiệu của bệnh? Bệnh có thể chữa khỏi hay không?

Hồng cầu hình miệng (stomatocyte) là một trong những dạng hồng cầu bị biến dạng (poikilocyte) ít gặp. Đặc trưng bởi những tế bào hồng cầu có vùng trung tâm nhợt nhạt, hình khe ngang như miệng đang cười và được phát hiện khi thực hiện phết máu ngoại vi. Khi lơ lửng trong huyết tương, những tế bào này trông như một cái bát.
Hồng cầu hình miệng hình thành có thể do khiếm khuyết của cấu trúc màng hồng cầu, dẫn đến tăng tính thấm đối với natri và kali. Nguyên nhân có thể do di truyền hoặc một số yếu tố thứ phát như các rối loạn về máu, xơ gan do rượu hoặc ngộ độc rượu cấp tính.
Hồng cầu hình miệng di truyền (HSt) là bệnh lý di truyền trội trên nhiễm sắc thể thường ít gặp và xảy khi có rối loạn protein màng tế bào hồng cầu. Bệnh đặc trưng qua tình trạng rò rỉ natri và kali của màng huyết tương, khiến tế bào hồng cầu bị biến dạng với khe hở ở vùng trung tâm. Điều này có thể dẫn đến phản ứng bất thường của hồng cầu với những thay đổi về nhiệt độ, tăng nguy cơ thiếu máu, tan máu. (1)
Dựa trên nồng độ Na+ và K+ trong hồng cầu hình miệng, bệnh thường được phân thành hai loại chính gồm:
Bệnh hồng cầu hình miệng di truyền thể mất nước (DHSt) có tỷ lệ mắc bệnh là 1/8.000 – 55.000 người. Ở thể bệnh này, tính thấm cation của hồng cầu bị rối loạn, làm giảm độ bền thẩm thấu và gây mất nước, dẫn đến tan máu còn bù mức độ nhẹ đến trung bình. Mặt khác, khi bảo quản mẫu máu ở nhiệt độ phòng có thể ghi nhận hiện tượng tăng kali giả. (2)
Dạng hồng cầu hình miệng di truyền thừa nước (OHSt) là thể bệnh ít gặp hơn với tỷ lệ mắc 1/1.000.000 người. Ở thể OHSt, tính thấm của màng hồng cầu với các cation đơn trị tăng, khiến nồng độ Na+ nội bào tăng và nồng độ K+ giảm, dẫn đến nước tràn vào tế bào. Hậu quả làm hồng cầu dễ vỡ và sớm bị phá hủy trong lách.
Cơ chế gây HSt liên quan đến sự thiếu hụt hoặc mất protein stomatin (band 7.2b), một loại protein màng. Điều này gây rối loạn tính thấm màng tế bào hồng cầu với các cation đơn trị như Na+ và K+, sau đó là sự hình thành hồng cầu hình miệng. Nguyên nhân chủ yếu dẫn đến tình trạng này do đột biến gen làm thay đổi protein stomatin. Tùy theo từng dạng bệnh, có những gen có thể gây đột biến như:
Về kiểu di truyền, bệnh thuộc dạng di truyền trội trên nhiễm sắc thể thường. Điều này có nghĩa là nếu ba hoặc mẹ mang gen đột biến, con cái sẽ có 50% nguy cơ mắc bệnh hồng cầu hình miệng di truyền. (3)
Triệu chứng lâm sàng của HSt phần lớn không rõ ràng và thay đổi tùy theo thể bệnh. Một số người bệnh có thể gặp những biểu hiện liên quan đến chứng thiếu máu tan máu như mệt mỏi, xanh xao, nhịp tim nhanh, khó thở, vàng da, lách to… Tình trạng tan máu kéo dài làm tăng nguy cơ hình thành sỏi mật. Thông thường, người bệnh được nghi ngờ mắc hồng cầu hình miệng di truyền khi phát hiện bất thường trong kết quả xét nghiệm máu và những xét nghiệm cận lâm sàng khác. (4)

Bệnh hồng cầu hình miệng di truyền ít gây ra triệu chứng lâm sàng rõ rệt. Việc phát hiện bệnh chủ yếu dựa trên các phương pháp cận lâm sàng như:
Bệnh hồng cầu hình miệng di truyền hiện chưa có phương pháp điều trị đặc hiệu nhưng có thể kiểm soát triệu chứng và phòng tránh nguy cơ gặp biến chứng. Nhìn chung, tiên lượng ở người mắc HSt tương đối tốt nếu được phát hiện, can thiệp sớm, theo dõi sức khỏe định kỳ và quản lý biến chứng sỏi mật (nếu có). Những phương pháp hỗ trợ điều trị có thể gồm:
HỆ THỐNG BỆNH VIỆN ĐA KHOA TÂM ANH
Bệnh hồng cầu hình miệng di truyền không thể chữa khỏi hoàn toàn nhưng có thể được kiểm soát bằng những phương pháp thích hợp. Do không có triệu chứng lâm sàng rõ rệt, cách tối ưu để phát hiện sớm HSt là khám sức khỏe định kỳ 1 – 2 lần mỗi năm. Nếu cảm thấy mệt mỏi, da dẻ xanh xao, khó thở hoặc gặp những dấu hiệu bất thường khác, người bệnh nên nhanh chóng đến BVĐK Tâm Anh hoặc cơ sở y tế uy tín để được khám, chẩn đoán và can thiệp kịp thời.